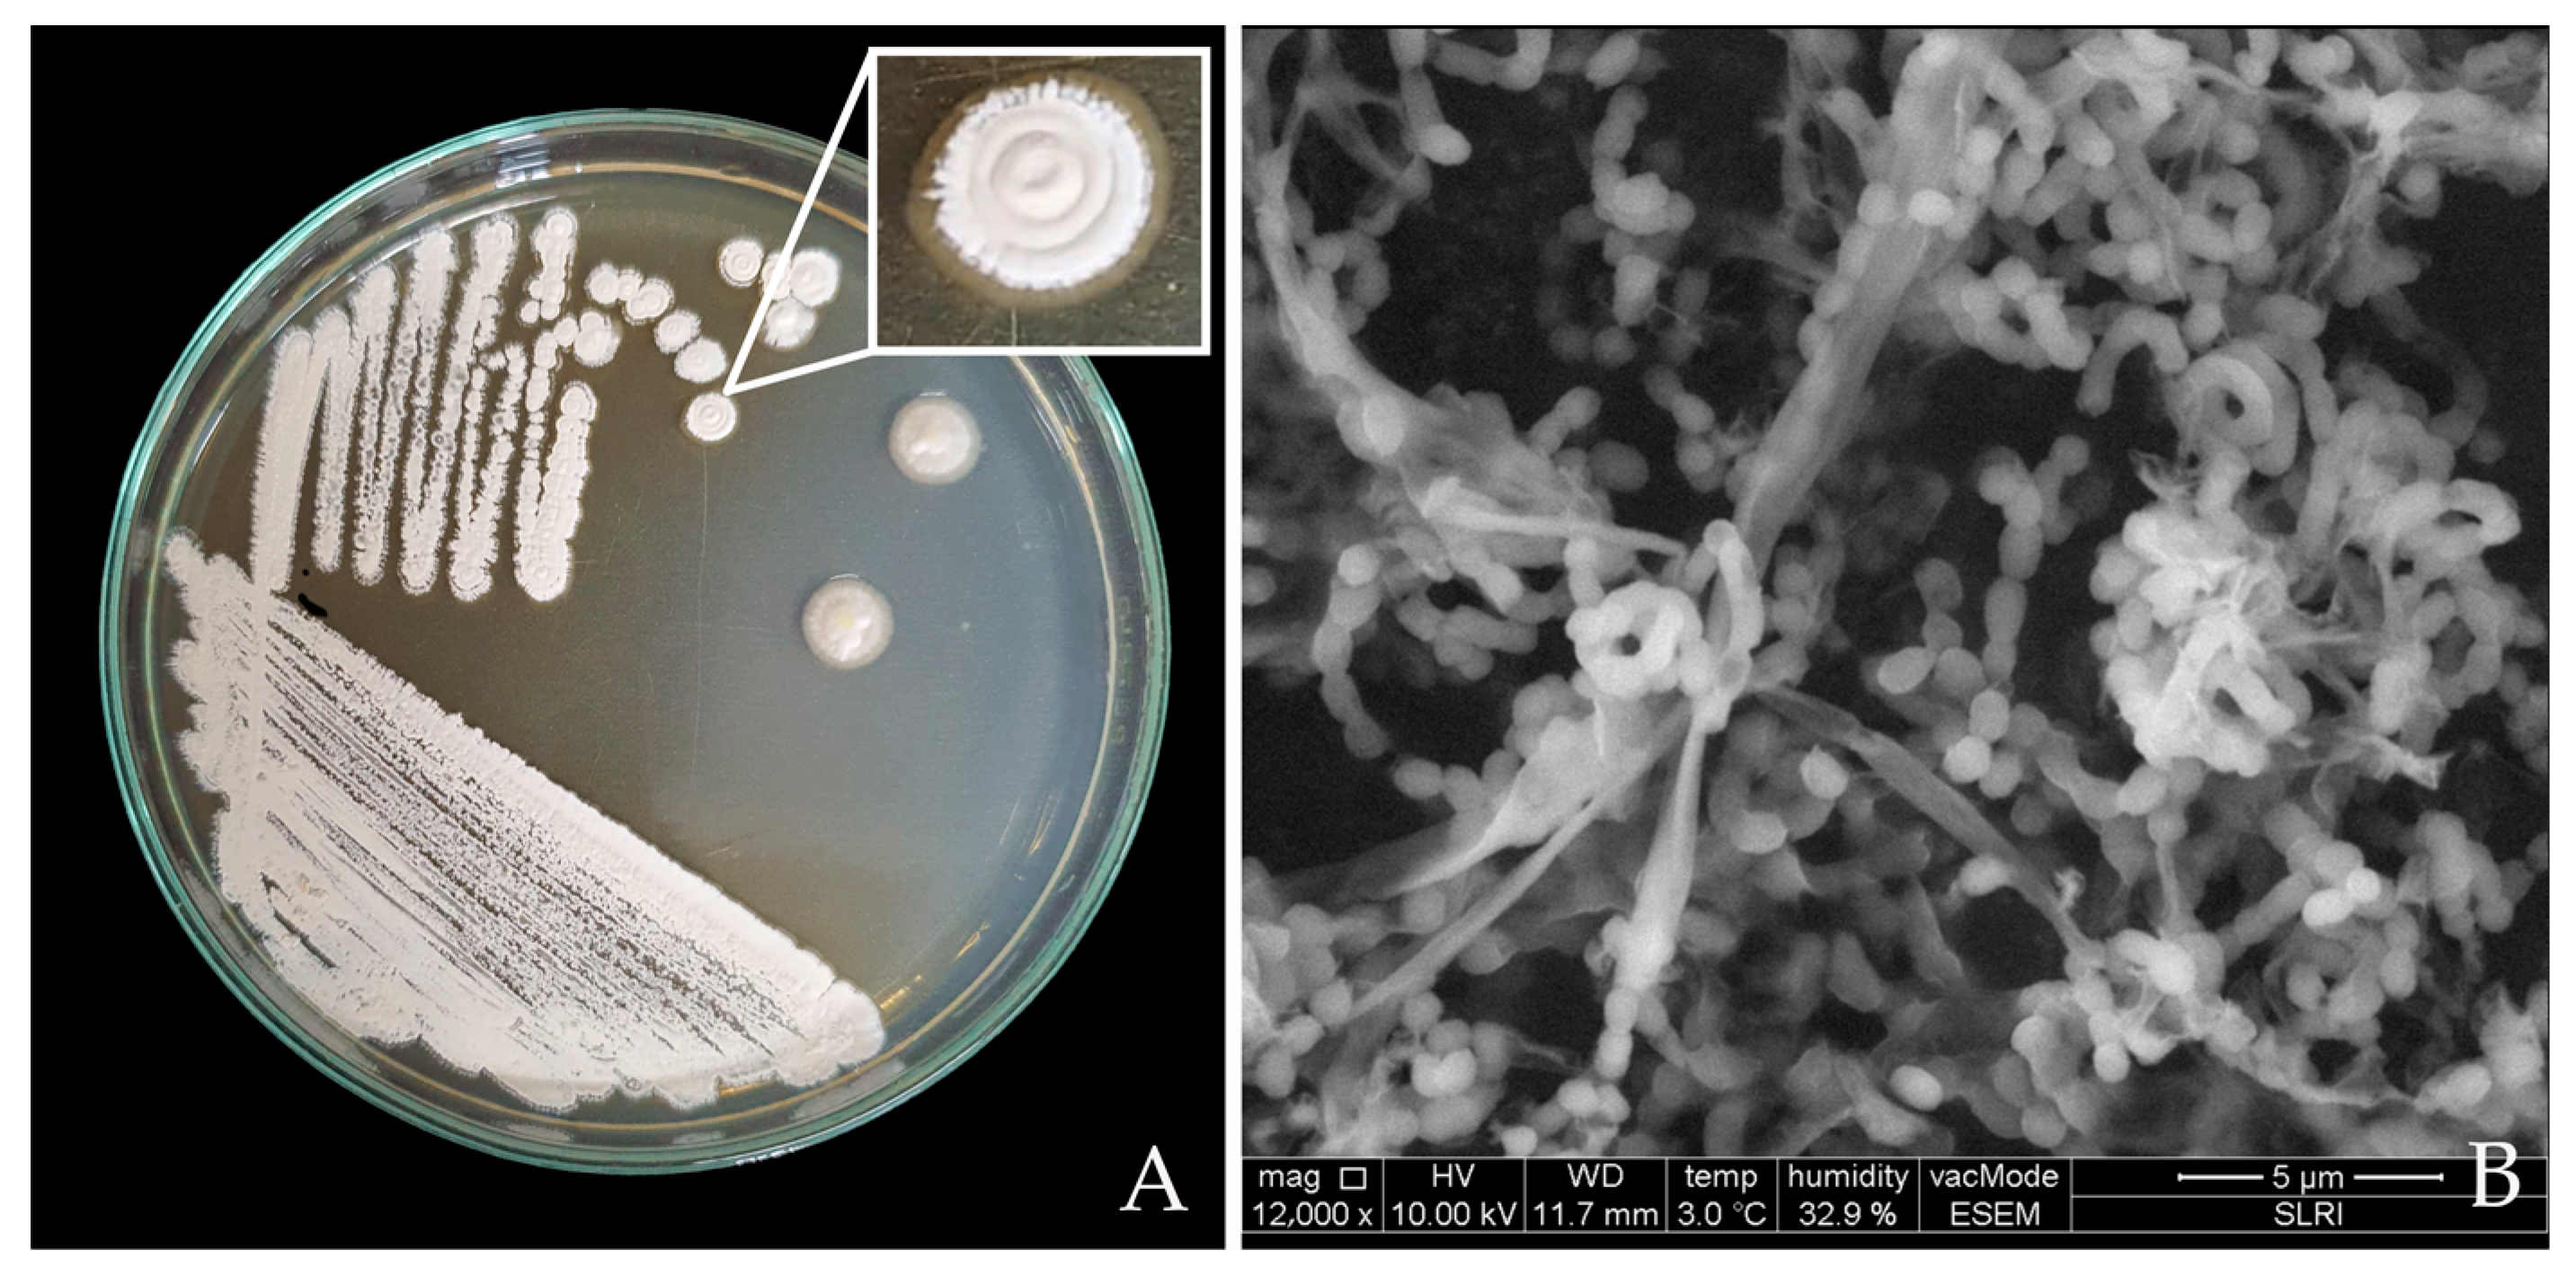
Horticulturae 09 00766 g002 Horticulturae 09 00766 g002

Plant Growth Promoting and Colonization of Endophytic Streptomyces albus CINv1 against Strawberry Anthracnose
Abstract
1. Introduction
2. Materials and Methods
2.1. Confirmation of Strawberry Anthracnose Fungal Pathogen
Isolation, Pathogenicity Tests, and Identification of Colletotrichum sp.
2.2. Characteristic Identification of Endophytic Streptomyces CINv1
2.2.1. Re-Isolation and Morphological Study of Endophytic Streptomyces CINv1
2.2.2. Molecular Identification of Endophytic Streptomyces CINv1
2.2.3. Inhibition Efficiency of Streptomyces CINv1 on the Radial Growth of Colletotrichum sp. Isolate CA0110
2.2.4. Scanning Electron Microscopy (SEM)
2.3. Plant Growth Promoting Activities
2.3.1. Phosphate and Potassium Solubilization Ability
2.3.2. Nitrogen Fixation
2.3.3. Siderophore Production
2.3.4. Auxin Quantification
2.4. Hydrolytic Enzyme Production
2.4.1. Detection of Protease Synthesis
2.4.2. Detection of Cellulase Synthesis
2.4.3. Detection of Chitinase Synthesis
2.4.4. Detection of Amylase Synthesis
2.5. Plant Growth-Promoting Activity in Tissue Culture Conditions
2.5.1. Preparation of Strawberry Plantlets
2.5.2. In Vitro Plant Growth Promotion Traits
2.5.3. Plant Growth Promotion Traits and Biological Control in Greenhouse Conditions
2.6. The Study of Colonization of Streptomyces CINv1
2.7. Screening of Secondary Metabolites Produced by Streptomyces CINv1
2.8. Statistical Analysis
3. Results
3.1. Identification of Strawberry Anthracnose Fungal Pathogen
Isolation and Identification of Colletotrichum sp.
3.2. Characteristic Identification of Streptomyces albus CINv1
3.2.1. Morphology of Streptomyces CINv1
3.2.2. Identification and Phylogenetic Tree of Streptomyces CINv1 Strain
3.2.3. Antifungal Activity of Streptomyces albus CINv1 on the Radial Growth of Colletotrichum sp. CA0110
3.3. Plant Growth-Promotion Activities
3.3.1. Phosphate and Potassium Solubilization Assay
3.3.2. Nitrogen Fixation
3.3.3. Siderophore Production
3.3.4. Indole-3-Acetic Acid (IAA) Determination
3.4. Hydrolytic Enzyme Production
3.5. Plant Growth Promotion Activities
3.5.1. Plant Growth Promotion Activities in Tissue Culture Conditions
3.5.2. Plant Growth Promotion and Biological Control in Greenhouse Conditions
3.6. Colonization Study of Streptomyces albus CINv1
3.7. Identification of Streptomyces albus CINv1 Metabolites
4. Discussion
5. Conclusions
Author Contributions
Funding
Data Availability Statement
Acknowledgments
Conflicts of Interest
References
- Zhimo, V.Y.; Kumar, A.; Biasi, A.; Salim, S.; Feygenberg, O.; Toamy, M.A.; Abdelfattaah, A.; Medina, S.; Freilich, S.; Wisniewski, M.; et al. Compositional shifts in the strawberry fruit microbiome in response to near-harvest application of Metschnikowia fructicola, a yeast biocontrol agent. Postharvest Biol. Technol. 2021, 175, 111469. [Google Scholar] [CrossRef]
- Kumvinit, A.; Akarapisan, A. Identification of Colletotrichum acutatum and screening of antagonistic bacteria isolated from strawberry in Chiang Mai, Thailand. J. Agric. Technol. 2016, 12, 693–706. [Google Scholar]
- Thammasophon, T.; Pusadee, T.; Bundithya, W.; Naphrom, D. Effects of Vernalization on Off–Season Flowering and Gene Expression in Sub-Tropical Strawberry cv. Pharachatan 80. Horticulturae 2023, 9, 87. [Google Scholar] [CrossRef]
- Singbanha, S.; Potapohn, N.; Smitamana, P. Anthracnose disease of strawberry and use of antagonistic microorganism for disease prevention. Asia Pac. J. Sci. Technol. 2017, 19, 371–384. [Google Scholar]
- Denoyes–Rothan, B.; Guerin, G.; Delye, C.; Smith, B.; Minz, D.; Maymon, M. Genetic diversity and pathogenic variability among isolates of Colletotrichum species from strawberry. Phytopathology 2003, 93, 219–288. [Google Scholar] [CrossRef] [PubMed]
- Than, P.P.; Jeewon, P.; Hyde, K.D.; Pongsupasamit, S.; Mongkolporn, O.; Taylor, P.W.J. Caracterization and pathogenicity of Colletotrichum species associated with anthracnose on chilli (Capsicum spp.) in Thailand. Plant Pathol. 2008, 57, 562–572. [Google Scholar] [CrossRef]
- Ciofini, A.; Negrini, F.; Baroncelli, R.; Baraldi, E. Management of Post-Harvest Anthracnose: Current Approaches and Future Perspectives. Plants 2022, 11, 1856. [Google Scholar] [CrossRef]
- Chung, P.C.; Wu, H.Y.; Wang, Y.W.; Ariyawansa, H.A.; Hu, H.P.; Hung, T.H. Diversity and pathogenicity of Colletotrichum species causing strawberry anthracnose in Taiwan and description of a new species, Colletotrichum miaoliense sp. nov. Sci. Rep. 2020, 10, 14664. [Google Scholar] [CrossRef]
- Zivkovic, S.; Stojanovic, S.; Ivanovic, Z.; Gavriloviv, V.; Tatjana, P.; Jelica, B. Screening of antagonistic activity of microorganisms against Colletotrichum acutatum and Colletotrichum gloeosporioides. Arch. Biol. Sci. Belgrade 2010, 62, 611–623. [Google Scholar] [CrossRef]
- Kim, H.J.; Lee, E.J.; Park, S.H.; Lee, H.S.; Chung, N. Biological control of anthracnose (Colletotrichum gloeosporioides) in pepper and cherry tomato by Streptomyces sp. A1022. J. Agric. Sci. 2014, 6, 54. [Google Scholar] [CrossRef]
- Rashid, M.; Kabir, H.; Hossain, M.; Bhuiyan, R.; Iqbal Khan, A.I. Eco-Friendly Management of Chilli Anthracnose (Colletotrichum capsici). Int. J. Plant Pathol. 2015, 6, 1–11. [Google Scholar] [CrossRef]
- Saengnak, V.; Jaipin, W.; Nalumpang, S. Evaluation of Streptomyces sp. culture media extracts for control of strawberry anthracnose disease. J. Agric. Technol. 2014, 10, 105–117. [Google Scholar]
- Kumar, A.; Droby, S.; Singh, V.K.; Singh, S.K.; White, J.F. 1-Entry, colonization, and distribution of endophytic microorganisms in plants. Microb. Endophytes 2020, 1–33. [Google Scholar] [CrossRef]
- Muresan, L.E. Culturable Bacterial and Fungal Endophytes from Apple Tissue and Their Potential for Biological Control of Venturia inaequalis. Master’s Thesis, The University of Guelph, Guelph, ON, Canada, December 2017. [Google Scholar]
- Tamosiune, I.; Staniene, G.; Haimi, P.; Stants, V.; Rugienius, R.; Baniulis, D. Endophytic Bacillus and Pseudomonas spp. modulate apple shoot growth, cellular redox balance, and protein expression under in vitro conditions. Front. Recent. Dev. Plant. Sci. 2018, 9, 889. [Google Scholar] [CrossRef] [PubMed]
- White, J.F.; Chang, X.; Kingsley, K.L.; Zhang, Q.; Chiaranunt, P.; Micci, A.; Velazquez, F.; Elmore, M.; Crane, S.; Li, S. Endophytic bacteria in grass crop growth promotion and biostimulation. Grass Res. 2021, 1, 1–9. [Google Scholar] [CrossRef]
- Sousa, J.A.J.; Olivares, F.L. Plant growth promotion by Streptomycetes: Ecophysiology, mechanisms, and applications. Chem. Biol. Technol. Agric. 2016, 3, 24. [Google Scholar] [CrossRef]
- Olanrewaju, O.S.; Babalola, O.O. Streptomyces: Implications and interactions in plant growth promotion. Appl. Microbiol. Biotechnol. 2019, 103, 1179–1188. [Google Scholar] [CrossRef]
- Viaene, T.; Langendries, S.; Beirinckx, S.; Maes, M.; Goormachtig, S. Streptomyces as a plant’s best friend? FEMS Microbiol. Ecol. 2016, 92, 1–8. [Google Scholar] [CrossRef]
- Adegboye, M.F.; Babalola, O.O. Taxonomy and ecology of antibiotic-producing actinomycetes. Afr. J. Agric. Res. 2012, 7, 2255–2261. [Google Scholar]
- Tyc, O.; Song, C.; Dickschat, J.S.; Vos, M.; Garbeva, P. The ecological role of volatile and soluble secondary metabolites produced by soil bacteria. Trends Microbiol. 2017, 25, 280–292. [Google Scholar] [CrossRef]
- Franco-Correa, M.; Quintana, A.; Duque, C.; Suarez, C.; Rodríguez, M.X.; Barea, J.M. Evaluation of actinomycete strains for key traits related with plant growth promotion and mycorrhiza-helping activities. Appl. Soil. Ecol. 2010, 45, 209–217. [Google Scholar] [CrossRef]
- Loria, R.; Kers, J.; Joshi, M. Evolution of Plant Pathogenicity in Streptomyces. Annu. Rev. Phytopathol. 2006, 44, 69–87. [Google Scholar] [CrossRef] [PubMed]
- Hopwood, D.A. Streptomyces in Nature and Medicine. In The Antibiotic Makers; Oxford University Press: New York, NY, USA, 2007; Volume 63, pp. 1–250. [Google Scholar]
- Van der Meij, A.; Willemse, J.; Schneilderberg, M.A.; Geurts, R.; Raijmakers, J.M.; van Wezel, G.P. Inter-and intracellular colonization of Arabidopsis roots by endophytic actinobacteria and the impact of plant hormones on their antimicrobial activity. Mol. Biotechnol. 2018, 111, 679–690. [Google Scholar] [CrossRef] [PubMed]
- Rothrock, C.S.; Gottlieb, D. Role of antibiosis in antagonism of Streptomyces hygroscopicus var. geldanus to Rhizoctonia solani in soil. Can. J. Microbiol. 1984, 30, 1440–1447. [Google Scholar] [CrossRef]
- El-tarabily, K.A. Rhizosphere-competent isolates of Streptomycete and non-Streptomycete actinomycetes capable of producing cell-wall-degrading enzymes to control Pythium aphanidermatum damping-off disease of cucumber. Can. J. Bot. 2006, 84, 211–222. [Google Scholar] [CrossRef]
- Pangesti, N.; Pineda, A.; Pieteres, C.M.J.; Dicke, M.; van Loon, J.A. Two-way plant-mediated interactions be-tween root-associated microbes and insects: From ecology to mechanisms. Front. Plant. Sci. 2013, 4, 414. [Google Scholar] [CrossRef]
- Kumar, M.; Poonama; Ahmad, S.; Singha, R.P. Plant growth promoting microbes: Diverse roles for sustainable and eco-friendly agriculture Mahesh. Energy Nexus 2022, 7, 100133. [Google Scholar] [CrossRef]
- Gunnell, P.S.; Gubler, W.D. Taxonomy and morphology of Colletotrichum acutatum. Mycologia 1992, 84, 157–165. [Google Scholar] [CrossRef]
- Peres, N.A.; Timmer, L.W.; Adaskaveg, V.E.; Correll, L.C. Lifestiles of Colletotrichum acutatum. Plant. Dis. 2005, 89, 784–796. [Google Scholar] [CrossRef]
- Wang, N.Y.; Forcelini, B.B.; Peres, N.A. Anthracnose fruit and root necrosis of strawberry are caused by a dominant species within the Colletotrichum acutatum species complex in the United States. Phytopathology 2019, 109, 1293–1301. [Google Scholar] [CrossRef]
- Cacciola, S.O.; Gilardi, G.; Faedda, R.; Schena, L.; Pane, A.; Garibaldi, A.; Gullino, M.L. Characterization of Colletotrichum ocimi Population Associated with Black Spot of Sweet Bacil (Ocimum basilicum) in Northern Italy. Plants 2020, 9, 654. [Google Scholar] [CrossRef] [PubMed]
- Tanapichatsakul, C.; Pansanit, A.; Monggoot, S.; Brooks, S.; Prachya, S.; Kittakoop, P.; Panuwet, P.; Pripdeevech, P. Antifungal activity of 8-methoxynaphthalen1-ol isolated from the endophytic fungus Diatrype palmicola MFLUCC 17-0313 against the plant pathogenic fungus Athelia rolfsii on tomatoes. PeerJ 2020, 8, e9103. [Google Scholar] [CrossRef] [PubMed]
- Moreira, R.R.; Natalia, A.P.; May De Mio, L.L. Colletotrichum acutatum and C. gloeosporioides Species Complexes Associated with Apple in Bracil. Plant. Dis. 2019, 103, 268–275. [Google Scholar] [CrossRef]
- Moran, P.; Coats, B. Biological Sample Preparation for SEM Imaging of Porcine Retina. Microsc. Today 2012, 20, 28–31. [Google Scholar] [CrossRef]
- Taechowisan, T.; Peberdy, J.F.; Lumyong, S. Isolation of endophytic actinomycetes from selected plants and their antifungal activity. World J. Microbiol. Bio-Technol. 2003, 19, 381–385. [Google Scholar] [CrossRef]
- Chaiharn, M.; Theantana, T.; Pathom-aree, W. Evaluation of Biocontrol Activities of Streptomyces spp. against Rice Blast Disease Fungi. Pathogens 2020, 9, 126. [Google Scholar] [CrossRef]
- Hata, E.M.; Sijam, K.; Ahmad, Z.A.M.; Yusof, M.T.; Azman, N.A. In votro Antimicrobial Assay of Actinomyces in Rice Against Xanthomonas oryzae pv. oryzicola and as Potential Plant Growth Promoter. Braz. Arch. Biol. Technol. Int. J. 2015, 58, 821–832. [Google Scholar] [CrossRef]
- Tamura, K.; Peterson, D.; Perterson, N.; Stecher, G.; Nei, M.; Kumar, S. MEGA5: Molecular evolutionary genetics analysis using maximum likelihood, evolutionary distance, and maximum parsimony methods. Mol. Biol. Evol. 2011, 28, 2731–2739. [Google Scholar] [CrossRef]
- Katoh, K.; Rozewicki, J.; Yamada, K.D. MAFFT online service: Multiple sequence alignment, interactive sequence choice, and visualization. Brief. Bioinform. 2018, 20, 1160–1166. [Google Scholar] [CrossRef]
- Agarwal, M.; Dheemana, S.; Dubeya, R.C.; Kumarb, P.; Maheshwaria, D.K.; Bajpai, V.K. Differential antagonistic responses of Bacillus pumilus MSUA3 against Rhizoctonia solani and Fusarium oxysporum causing fungal diseases in Fagopyrum esculentum Moench. Microbiol. Res. 2017, 205, 40–47. [Google Scholar] [CrossRef]
- Shimizu, M.; Nakagawa, Y.; Sato, Y.; Furumai, T.; Igarashi, Y.; Onaka, H.; Yoshida, R.; Kunoh, H. Studies on endophytic actinomycetes (I) Streptomycetes sp. isolated from rhododendron and its antifungal activity. J. Gen. Plant. Pathol. 2000, 66, 360–366. [Google Scholar] [CrossRef]
- Khamna, S.; Yokota, A.; Lumyong, S. Actinomycetes isolated from medicinal plant rhizosphere soils: Diversity and screening of antifungal compounds, indole-3-acetic acid, and siderophore production. World J. Microbiol. Bio-Technol. 2009, 25, 649–655. [Google Scholar] [CrossRef]
- Hallett, I.C.; Boyd-Wilson, K.S.H.; Everett, K.R. Microscope methods for observation of the phylloplane flora. N. Z. Plant. Prot. 2010, 63, 15–23. [Google Scholar] [CrossRef]
- Mubarik, N.R.; Wibowo, R.H.; Angraini, E.; Mursyida, E.; Wahdi, E. Exploration of Bacterial Diversity at Cirebon Quarry; Final Report; Bogor Agricultural University: Bogor, Indonesia, 2014. [Google Scholar]
- Prashanth, S.; Mathivanan, N. Growth promotion of groundnut by IAA producing rhizobacteria Bacillus licheniformis MML2501. Arch. Phytopathol. Plant. Prot. 2010, 43, 191–208. [Google Scholar] [CrossRef]
- Park, M.; Kim, C.; Yang, J.; Lee, H.; Shin, W.; Kim, S.; Sa, T. Isolation and characterization of diazotrophic growth promoting bacteria from rhizosphere of agricultural crops of Korea. Microbiol. Res. 2005, 160, 127–133. [Google Scholar] [CrossRef]
- Srimathi, K.; Ann Suji, H. Siderophores Detection by using Blue Agar CAS Assay Methods. Int. J. Sci. Res. Biol. Sci. 2018, 5, 80–185. [Google Scholar] [CrossRef]
- Lin, L.; Xu, X. Indole-3-Acetic Acid Production by Endophytic Streptomyces sp. En-1 Isolated from Medicinal Plants. Curr. Microbiol. 2013, 67, 209–217. [Google Scholar] [CrossRef]
- Mamangkeya, J.; Suryanto, D.; Munir, E.; Mustopa, A.Z.; Siberoc, M.T.; Mendese, L.W.; Hartanto, A.; Taniwan, S.; Ek-Ramos, M.J.; Harahap, A.; et al. Isolation and enzyme bioprospection of bacteria associated to Bruguiera cylindrica, a mangrove plant of North Sumatra, Indonesia. Biotechnol. Rep. 2021, 30, e00617. [Google Scholar] [CrossRef]
- Naing, A.H.; Kim, S.H.; Chung, M.Y.; Park, S.K.; Kim, C.K. In vitro propagation method for production of morphologically and genetically stable plants of different strawberry cultivars. Plant Methods 2019, 15, 36. [Google Scholar] [CrossRef]
- Sirijan, M.; Pipattanawong, N.; Chaiprasart, P. Effect of 1-naphthalene acetic acid and 6-benzyladenine on micropropagation of strawberry cultivar ‘Praratchatan No.80’. Agric. Nat. Resour. 2019, 53, 355–363. [Google Scholar]
- Dias, A.C.F.; Costa, F.E.C.; Andreote, F.D.; Lacava, P.T.; Teixeira, M.A.; Assumpcao, L.C.; Arau´jo, W.L.; Azevedo, J.L.; Melo, I.S. Isolation of micropropagated strawberry endophytic bacteria and ssessment of their potential for plant growth promotion. World J. Microbiol. Biotechnol. 2009, 25, 189–195. [Google Scholar] [CrossRef]
- Awla, H.K.; Kadir, J.; Othman, R.; Rashid, T.S.; Wong, M.Y. Bioactive Compounds Produced by Streptomyces sp. Isolate UPMRS4 and Antifungal Activity against Pyricularia oryzae. Am. J. Plant. Sci. 2016, 7, 1077–1085. [Google Scholar] [CrossRef]
- Lahlali, R.; Ezrari, S.; Radouane, N.; Kenfaoui, J.; Esmaeel, Q.; El Hamss, H.; Belabess, Z.; Barka, E.A. Biological Control of Plant Pathogens: A Global Perspective. Microorganisms 2022, 10, 596. [Google Scholar] [CrossRef]
- Kwon, J.-H.; Won, S.-J.; Moon, J.-H.; Lee, U.; Park, Y.-S.; Maung, C.E.H.; Ajuna, H.B.; Ahn, Y.S. Bacillus licheniformis PR2 Controls Fungal Diseases and Increases Production of Jujube Fruit under Field Conditions. Horticulturae 2021, 7, 49. [Google Scholar] [CrossRef]
- Yang, X.; Zhang, L.; Xiang, Y.; Du, L.; Huang, X.; Liu, Y. Comparative transcriptome analysis of Sclerotinia sclerotiorum revealed its response mechanisms to the biological control agent, Bacillus amyloliquefaciens. Sci. Rep. 2020, 10, 12576. [Google Scholar] [CrossRef] [PubMed]
- Rahman, M.A.; Kadir, J.; Mahmud, T.M.M.; Abdul Rahman, R.; Begum, M.M. Screening o Antagonistic Bacteria for Biocontrol Activities on Colletotrichum gloeosporioides in Papaya. Asian J. Plant. Sci. 2007, 6, 12–20. [Google Scholar] [CrossRef]
- Schleissner, C.; Perez, M.; Losada, A.; Rodriguez, P.; Crespo, C.; Zuniga, P.; Fernandez, R.; Reyes, F.; Calle, F.D.L. Antitumor Actinopyranonas Produce by Streptomyces albus POR-04-15-053 Isolated from a Marine Sediment. J. Nat. Prod. 2011, 74, 1590–1596. [Google Scholar] [CrossRef]
- Israni, N.; Thapa, S.; Shivakumar. Biolytic extraction of poly (3-hydroxybutyrate) from Bacillus megaterium Ti3 using the lytic enzyme of Streptomyces albus Tia1. J. Genet. Eng. Biotechnol. 2018, 16, 265–271. [Google Scholar] [CrossRef]
- Gopalakrishnan, S.; Sharma, R.; Srinivas, V.; Naresh, N.; Mishra, S.P.; Ankati, S.; Pratyusha, S.; Govindaraj, M.; Gonzalez, S.V.; Nervik, S.; et al. Identification and Characterization of a Streptomyces albus Strain and Its Secondary metabolite Organophosphate against Charcoal Rot of Sorghum. Plants 2020, 9, 1727. [Google Scholar] [CrossRef]
- Prapagdee, B.; Kuekulvong, C.; Mongkolsuk, S. Antifungal Potential of Extracellular Metabolites Produced by Streptomyces hygroscopicus against Phytopathogenic Fungi. Int. J. Biol. Sci. 2008, 4, 330–337. [Google Scholar] [CrossRef]
- Araujo, N.M.P.; Arruda, H.S.; Dos Santos, F.N.; de Morais, D.R.; Pereira, G.A.; Pastore, G.M. LC-MS/MS screening and identification of bioactive compounds in leaves, pulp and seed from Eugenia calycina Cambess. Food Res. Int. 2020, 137, 109556. [Google Scholar] [CrossRef] [PubMed]
- Vurukonda, S.S.K.P.; Giovanardi, D.; Stefani, E. Plant Growth Promoting and Biocontrol Activity of Streptomyces spp. as Endophytes. Int. J. Mol. Sci. 2018, 19, 952. [Google Scholar] [CrossRef] [PubMed]
- Hassan, N.; Nakasuji, S.; Elsharkawy, M.M.; Naznin, H.A.; Kubota, M.; Ketta, H.; Shimizu, M. Biocontrol Potential of an Endophytic Streptomyces sp. Strain MBCN152-1 against Alternaria brassicicola on Cabbage Plug Seedlings. Microbes Environ. 2017, 32, 133–141. [Google Scholar] [CrossRef]
- Ramos-Bell, S.; Hernández-Montiel, L.G.; Velázquez-Estrada, R.M.; Herrera-González, J.A.; Gutiérrez-Martínez, P. Potential of Debaryomyces hansenii Strains on the Inhibition of Botrytis cinerea in Blueberry Fruits (Vaccinium corymbosum L.). Horticulturae 2022, 8, 1125. [Google Scholar] [CrossRef]
- Nagargade, M.; Tyagi, V.; Singh, M.K. Plant Growth-Promoting Rhizobacteria: A Biological Approach Toward the Production of Sustainable Agriculture. In Role of Rhizospheric Microbes in Soil; Springer: Berlin/Heidelberg, Germany, 2018; pp. 208–223. Available online: https://link.springer.com/chapter/10.1007/978-981-10-8402-7_8 (accessed on 15 May 2023).
- Chen, X.; Pizzatti, C.; Bonaldi, M.; Saracchi, M.; Erlacher, A.; Kunova, A.; Berg, G.; Cortes, P. Biological Control of Lettuce Drop and Host Plant Colonization by Rhizospheric and Endophytic Streptomycetes. Front. Microbiol. 2016, 7, 714. [Google Scholar] [CrossRef] [PubMed]
- Iqbal, S.; Hameed, S.; Shahid, M.; Hussain, K.; Ahmad, N.; Niaz, M. In vitro characterization of bacterial endophytes from tomato (Solanum lycopersicum L.) for phytobeneficial traits. Appl. Ecol. Environ. Res. 2017, 16, 1037–1051. [Google Scholar] [CrossRef]

| Treatment | Clear Zone (cm) | ||||
|---|---|---|---|---|---|
| Phosphate Solubilizing | Potassium Solubilizing | Nitrogen Fixation | Siderophore Production | IAA Production (µL/100 mL) | |
| Streptomyces albus CINv1 | 0.38 * ± 0.08 | 0.00 ± 0.00 | + | 0.52 * ± 0.06 | 31.6 ± 0.42 |
| Control | 0.00 ± 0.00 | 0.00 ± 0.00 | − | 0.00 ± 0.00 | − |
| Treatment | Mean Diameter of Halo (cm) | |||
|---|---|---|---|---|
| Protease | Cellulase | Chitinase | Amylase | |
| Streptomyces albus CINv1 | 1.07 * ± 0.08 | 0.76 * ± 0.08 | 0.32 * ± 0.006 | 0.55 * ± 0.03 |
| Control | 0.00 ± 0.00 | 0.00 ± 0.00 | 0.00 ± 0.00 | 0.00 ± 0.00 |
| Treatment | Plant Growth Parameters | |||||
|---|---|---|---|---|---|---|
| Number of Leaves | Number of Roots | Number of Stems | Canopy Height (cm) | Roots Length (cm) | Total Fresh Weight (g) | |
| S. albus CINv1 | 9.50 * ± 1.100 | 10.85 * ± 1.694 | 1.05 ns ± 0.224 | 5.27 * ± 0.529 | 6.81 * ± 0.786 | 0.66 * ± 0.181 |
| ddH2O | 6.50 ± 1.051 | 7.00 ± 1.974 | 1.00 ± 0.000 | 4.93 ± 0.464 | 5.95 ± 0.573 | 0.44 ± 0.081 |
| Compound | Formula | RT * | Mass | m/z | Ion Species |
|---|---|---|---|---|---|
| 2,4,6-Tribromophenol | C6H3Br3O | 0.956 | 327.7739 | 372.7722 | (M+HCOO)- |
| Simeconazole | C14H20FN3OSi | 3.863 | 293.1356 | 292.1283 | (M-H)- |
| Wybutoxine | C16H20N6O7 | 1.159 | 408.1397 | 453.1379 | (M+HCOO)- |
| Tetranactin | C44H72O12 | 3.428 | 792.4996 | 791.4915 | (M-H)- |
| Thiolactomycin | C11H14O2S | 3.223 | 210.0722 | 269.0862 | (M+CH3COO)- |
| Tolfenpyrad | C21H22Cl N3O2 | 4.722 | 383.1419 | 382.1327 | (M-H)- |
| Hypotaurocyamine | C3H9N3O2S | 1.018 | 151.0413 | 347.0811 | (2M+HCOO)- |
| Phytosulfokine b | C28H38N4O14S2 | 1.139 | 718.1708 | 359.0744 | (M-2H)-2 |
| Fusicoccin H | C26H42O8 | 4.116 | 406.1252 | 380.9792 | (M-H)- |
Disclaimer/Publisher’s Note: The statements, opinions and data contained in all publications are solely those of the individual author(s) and contributor(s) and not of MDPI and/or the editor(s). MDPI and/or the editor(s) disclaim responsibility for any injury to people or property resulting from any ideas, methods, instructions or products referred to in the content. |
© 2023 by the authors. Licensee MDPI, Basel, Switzerland. This article is an open access article distributed under the terms and conditions of the Creative Commons Attribution (CC BY) license (https://creativecommons.org/licenses/by/4.0/).
Share and Cite
Pupakdeepan, W.; Termsung, N.; Ruangwong, O.-U.; Kunasakdakul, K. Plant Growth Promoting and Colonization of Endophytic Streptomyces albus CINv1 against Strawberry Anthracnose. Horticulturae 2023, 9, 766. https://doi.org/10.3390/horticulturae9070766
Pupakdeepan W, Termsung N, Ruangwong O-U, Kunasakdakul K. Plant Growth Promoting and Colonization of Endophytic Streptomyces albus CINv1 against Strawberry Anthracnose. Horticulturae. 2023; 9(7):766. https://doi.org/10.3390/horticulturae9070766
Chicago/Turabian StylePupakdeepan, Waraporn, Natthida Termsung, On-Uma Ruangwong, and Kaewalin Kunasakdakul. 2023. "Plant Growth Promoting and Colonization of Endophytic Streptomyces albus CINv1 against Strawberry Anthracnose" Horticulturae 9, no. 7: 766. https://doi.org/10.3390/horticulturae9070766
APA StylePupakdeepan, W., Termsung, N., Ruangwong, O.-U., & Kunasakdakul, K. (2023). Plant Growth Promoting and Colonization of Endophytic Streptomyces albus CINv1 against Strawberry Anthracnose. Horticulturae, 9(7), 766. https://doi.org/10.3390/horticulturae9070766

